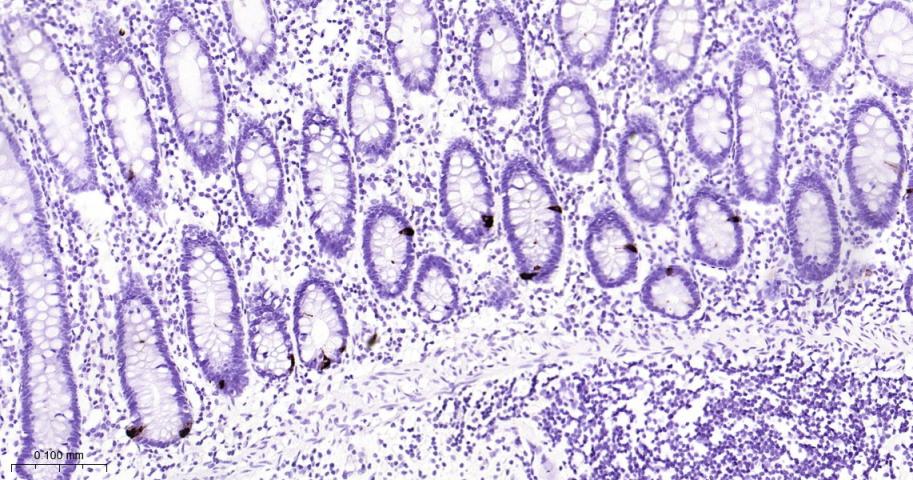
嗜铬粒素A重组兔单抗

嗜铬粒素A重组兔单抗
Rrmab?兔单抗

货号:bsm-60747R
产品详情
相关标记
相关产品
相关文献
常见问题
概述
产品编号
bsm-60747R
产品类型
重组兔单抗、mIHC精品抗体
英文名称
CHGA Recombinant Rabbit mAb
中文名称
嗜铬粒素A重组兔单抗
英文别名
CGA; PHE5; PHES; ChrA; CMGA_HUMAN; CHGA; Pituitary secretory protein I (SP-I); CMGA_MOUSE;
抗体来源
Rabbit
免疫原
A synthesized peptide derived from human Chromogranin A: 10-50
亚型
IgG
性状
Liquid
纯化方法
affinity purified by Protein A
克隆类型
Recombinant
克隆号
D11A7
理论分子量
48 kDa
浓度
1mg/ml
储存液
PBS, Glycerol, BSA.
研究领域
SWISS
Gene ID
保存条件
Shipped at 4℃. Store at -20℃ for one year. Avoid repeated freeze/thaw cycles.
注意事项
This product as supplied is intended for research use only, not for use in human, therapeutic or diagnostic applications.
数据库链接
产品介绍
嗜铬粒素A蛋白存在与很多组织中:胃肠道内分泌细胞和类癌、甲状旁腺、垂体前叶、肾上腺髓质、神经节、副神经节、胰岛、甲状腺C细胞等组织和其来源的肿瘤都表达该成分.嗜铬素A(CgA)属于可溶性的酸性蛋白,主要存在于神经内分泌细胞的分泌颗粒中,也存在于含有分泌颗粒的内分泌细胞和神经内分泌细胞来源的肿瘤细胞中。检测循环中的免疫反应CgA对神经内分泌瘤具有诊断意义。另外,CgA的免疫组织化学检测对鉴定来源于神经内分泌的肿瘤起到辅助作用。
背景资料
The protein encoded by this gene is a member of the chromogranin/secretogranin family of neuroendocrine secretory proteins. It is found in secretory vesicles of neurons and endocrine cells. This gene product is a precursor to three biologically active peptides; vasostatin, pancreastatin, and parastatin. These peptides act as autocrine or paracrine negative modulators of the neuroendocrine system. Other peptides, including chromostatin, beta-granin, WE-14 and GE-25, are also derived from the full-length protein. However, biological activities for these molecules have not been shown. [provided by RefSeq, Jul 2008].

产品应用
| 应用 | 已检合格种属 | 预测种属 | 推荐稀释比例 |
|---|---|---|---|
| WB | Mouse, Rat | Human | 1:500-2000 |
| IHC-P | Human, Mouse, Rat | 1:100-500 | |
| IHC-F | Human, Mouse, Rat | 1:100-500 | |
| IF | Human, Mouse, Rat | 1:100-500 |
交叉反应
交叉反应: Human, Mouse, Rat
相关产品
暂无相关产品
靶标
基因名
CHGA
蛋白名
Chromogranin-A
亚基
Interacts with SCG3.
亚细胞定位
Cytoplasmic vesicle, secretory vesicle lumen. Cytoplasmic vesicle, secretory vesicle membrane. Secreted. Note=Associated with the secretory granule membrane through direct interaction to SCG3 that in turn binds to cholesterol-enriched lipid rafts in intragranular conditions.
翻译后修饰
Sulfated on tyrosine residues and/or contains sulfated glycans.
O-glycosylated with core 1 or possibly core 8 glycans.
O-glycosylated with core 1 or possibly core 8 glycans.
相似性
Belongs to the chromogranin/secretogranin proteinfamily.
功能
Pancreastatin strongly inhibits glucose induced insulin release from the pancreas.
标记抗体
暂无标记数据
同靶标产品
暂无同靶标产品
相关文献
提示: 发表研究结果有使用 bsm-60747R 时请让我们知道,以便我们可以引用参考文章。作为回馈,资料提供者将获得我们送上的小礼品。
暂无相关文献
常见问题
暂无常见问题